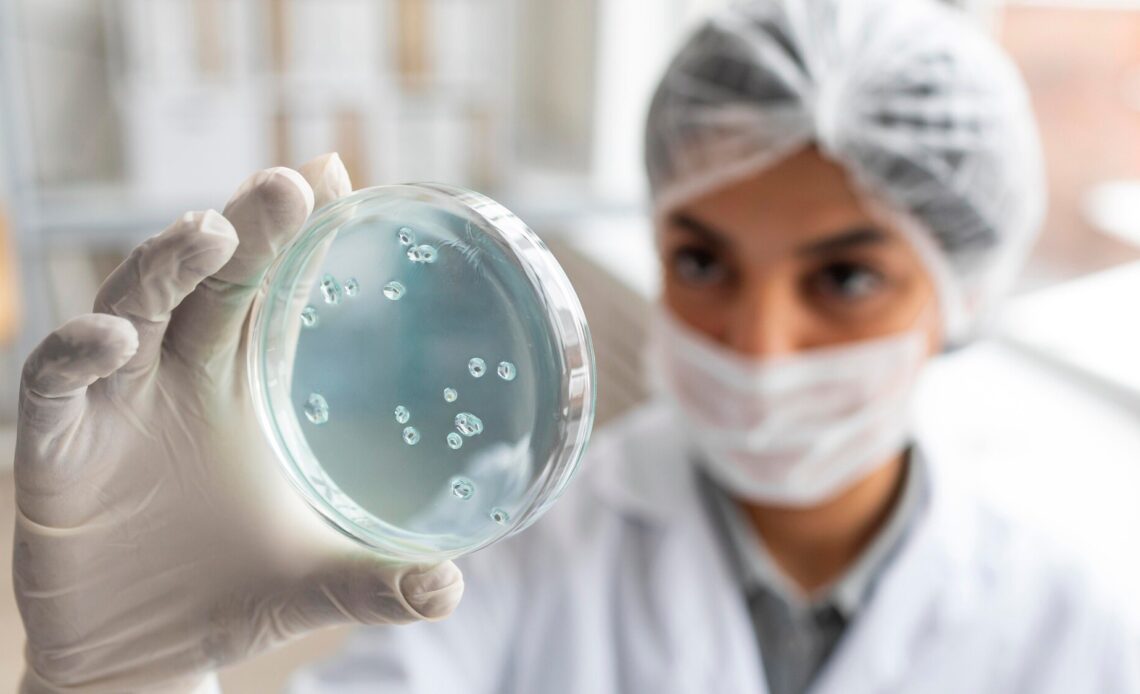

Se você vive gripado, enfrenta infecções com frequência ou sente que sua imunidade está sempre em baixa, é hora de acender o alerta. Esses sintomas, muitas vezes negligenciados, podem ser indícios de uma condição mais complexa: a Imunodeficiência Primária (IDP).
Quem faz o alerta é a Dra. Leila Borges, alergologista da Clínica IBIS, que explica que as IDPs são um grupo de doenças genéticas e crônicas que afetam o funcionamento do sistema imunológico. Ela explica que essas condições não se manifestam apenas por infecções repetidas, como se acreditava antigamente. Elas também podem surgir por meio de alergias graves, doenças autoimunes precoces e até uma maior susceptibilidade a certos tipos de câncer.
“Também podem ser aqueles pacientes que fazem febres recorrentes, que não conseguem identificar um diagnóstico”, complementa.

Segundo a especialista, alguns sinais de alerta devem ser levados a sério, como:
- Quatro ou mais otites em um ano
- Duas ou mais pneumonias no mesmo período
- Alergias múltiplas ou graves
- Febres recorrentes sem explicação
A médica reforça a importância do diagnóstico precoce, que pode prevenir complicações futuras e, em muitos casos, garantir um tratamento eficaz — inclusive com possibilidades de cura.
“É muito importante que esse diagnóstico seja feito de forma precoce, evitando assim que o paciente acabe evoluindo com comorbidades, e alguns deles têm tratamentos definitivos”, afirma.

A Clínica IBIS, referência em Salvador no cuidado com alergias e imunologia, está disponível para esclarecer dúvidas e realizar avaliações personalizadas. Se você ou alguém próximo apresenta esses sintomas com frequência, não hesite em buscar orientação médica.
Clínica IBIS • Centro de Terapia Assistida
Av. Tancredo Neves, 620, Salas 2803-2808, Edf. Mundo Plaza
Contato: 71 98410-5500 | @clinicaibis
Fotos: Banco de Imagens